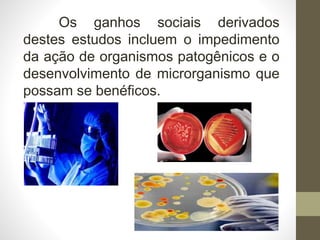
Os ganhos sociais derivados
destes estudos incluem o impedimento
da ação de organismos patogênicos e o
desenvolvimento de microrganismo que
possam se benéficos.

O documento introduz os conceitos básicos de microbiologia, incluindo que a microbiologia estuda organismos microscópicos como bactérias, fungos e vírus. Também discute as formas como doenças infecciosas podem ser transmitidas, incluindo por contato direto ou indireto, vetores como insetos, e veículos como água e alimentos contaminados.